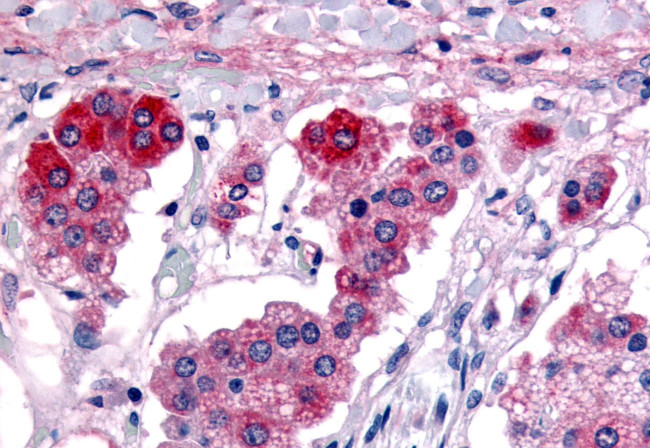
GPR182 Antibody in Immunohistochemistry (Paraffin) (IHC (P))

Search
Invitrogen
GPR182 Polyclonal Antibody
{{$productOrderCtrl.translations['antibody.pdp.commerceCard.promotion.promotions']}}
{{$productOrderCtrl.translations['antibody.pdp.commerceCard.promotion.viewpromo']}}
{{$productOrderCtrl.translations['antibody.pdp.commerceCard.promotion.promocode']}}: {{promo.promoCode}} {{promo.promoTitle}} {{promo.promoDescription}}. {{$productOrderCtrl.translations['antibody.pdp.commerceCard.promotion.learnmore']}}
产品信息
PA5-32812
种属反应
宿主/亚型
分类
类型
抗原
偶联物
形式
浓度
规格
纯化类型
保存液
内含物
保存条件
运输条件
RRID
产品详细信息
Percent identity with other species by BLAST analysis: Human, Gorilla, Gibbon, Monkey (100%); Marmoset, Bovine, Horse (89%); Elephant, Rabbit, Pig (83%).
For IHC(P), use heat induced antigen retrieval in pH 6.0 citrate buffer. After incubation with the primary antibody, slides were incubated with biotinylated secondary antibody, followed by alkaline phosphatase-streptavidin and chromogen.
靶标信息
Adrenomedullin (ADM) is a hypotensive peptide that belongs to a peptide superfamily, which includes the calcitonin gene-related peptide (CGRP) and amylin. ADM was originally identified in the adrenal medulla, where it is highly expressed. It is also produced by most contractile cells and is upregulated during sepsis and ischemia. Three distinct receptors have the ability to bind ADM and are designated ADM receptor (also designated L1), RDC-1 and the Calcitonin Receptor-Like Receptor (CRLR). The CRLR associates with receptor activity-modifying proteins (RAMPs), which determine the specificity of CRLR binding. Co-expression with RAMP1 results in CRLR binding to CGRP, whereas association with RAMP2 or 3 results in ADM binding. The ADM receptor, a seven transmembrane G protein-coupled receptor, specifically binds ADM and is highly expressed in heart, brain, skeletal muscle, the immune system, adrenal gland and liver. The ADM receptor mediates the signals produced by ADM through G proteins, which activate adenylate cyclase.
仅用于科研。不用于诊断过程。未经明确授权不得转售。
篇参考文献 (0)
生物信息学
蛋白别名: adrenomedullin receptor; Atypical chemokine receptor 5; G protein-coupled receptor 182; G-protein coupled receptor 182; HAMR; RAMR
基因别名: 7TMR; ACKR5; ADMR; AM-R; AMR; G10D; gamrh; GPR182; hrhAMR; L1-R
UniProt ID: (Human) O15218
Entrez Gene ID: (Human) 11318